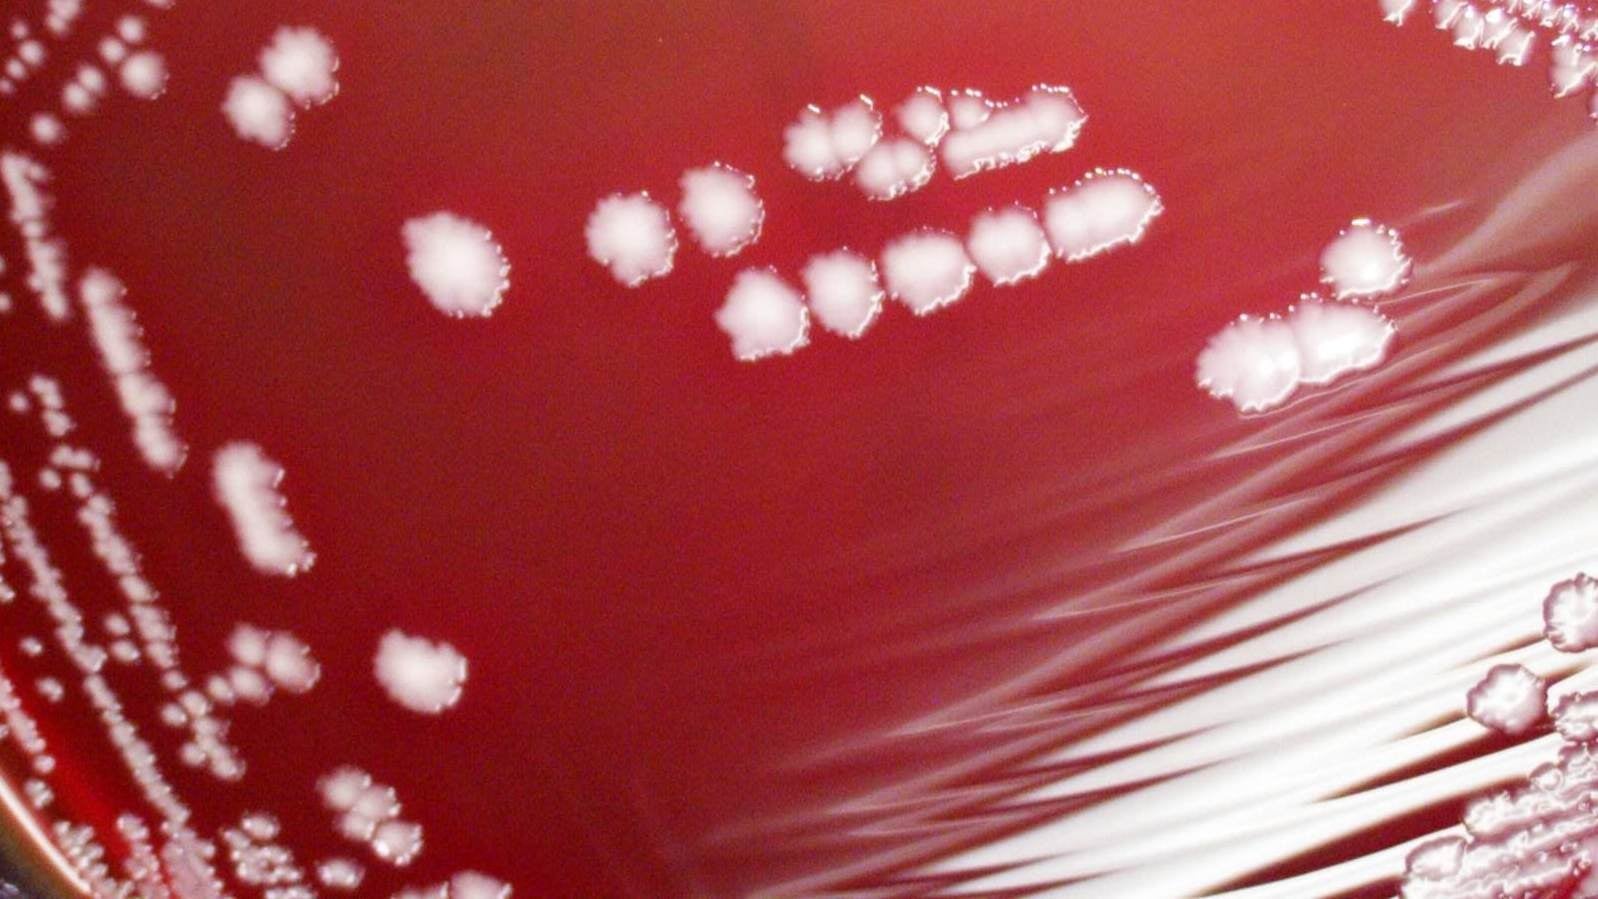
Yersinia pestis being grown in a petri dish.

You may have seen alarming headlines today warning of the “Black Death plague” that’s believed to have infected two people in China. But while there are real reasons for public health officials and residents in that area of the world to be concerned, there’s no reason to fear a deadly pandemic.
On Tuesday, health officials in Beijing announced that two people from the Inner Mongolia region of the country had recently sought care at a local hospital, where they were diagnosed with pneumonic plague. Though health officials said these two patients have since been quarantined and that there is an extremely low risk of further transmission, there have reportedly been fears of a possible outbreak reverberating throughout the country.
The disease we call plague is caused by a rod-shaped bacteria called Yersinia pestis. The bacteria can make us sick in three distinct ways, depending on how it enters and infects the body. When we get infected through contact with animals (usually the bite of a flea that had fed on another infected animal, like a rat), it typically goes after our lymph nodes and causes bubonic plague. When the bacteria is inhaled into our lungs, it causes pneumonic plague. More rarely, it can end up in our bloodstream, which is then known as septicemic plague.
https://gizmodo.com/ancient-black-plague-found-in-swedish-gravesite-1830907860
There isn’t always a concrete divide between these forms, since people with untreated bubonic plague can develop either pneumonic or septicemic plague. But people with pneumonic plague can also spread it directly to others through contagious airborne droplets loaded with plague bacteria. That’s why pneumonic plague is often so alarming when it shows up. And the political situation in China isn’t helping calm those fears.
The Chinese government is notoriously tight-lipped about things that might make it look bad, particularly outbreaks of infectious disease. And the New York Times reported Tuesday that the government has started to censor information and social media posts talking about the plague cases, including questions about why it took so long for the public to know about them. According to a doctor who claims to have initially treated the cases, the Times reported, the patients (a husband and wife) had first looked for care in Beijing on November 3, a week and a half ago.
But—and this is important—we’re not headed for the Black Death 2.0 here. In the past, pneumonic plague was always fatal within a day of symptoms arriving. But nowadays, antibiotics can treat all forms of the plague if it is caught early enough. According to the Centers for Disease Control and Prevention, the overall mortality rate for plague has sunk to around 10 percent from 1990 to 2010.
There are areas of the world, predominantly in Africa, where plague is endemic and regularly sickens people, and some experts have worried that it’s starting to reemerge in areas where it hadn’t shown up for a long time. But the living conditions that once made it a common source of pandemics, such as little to no sanitation, are no longer widespread. According to the World Health Organization, there were 3,248 cases of plague reported globally between 2010 to 2015, as well as 584 deaths. The U.S. gets a handful of plague cases every year as well, typically in the Southwest regions of the country.
None of this is to say that a potential outbreak of pneumonic plague in China isn’t worth caring about. But it’s important to keep some context in mind and not be frightened by alarmism. Just last winter, for instance, there may have been as many as 61,000 people who died of the common flu in the U.S. alone, yet only about half of us typically bother to get the flu vaccine.